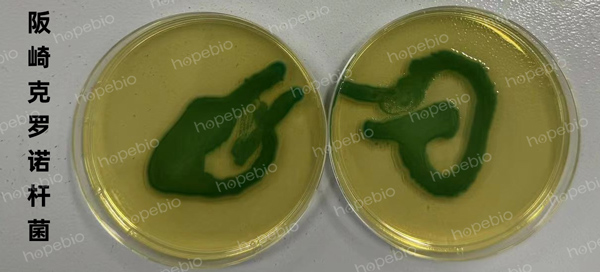

海博微信公众号
海博微信公众号
 海博天猫旗舰店
海博天猫旗舰店


 海博微信公众号
海博微信公众号
 海博天猫旗舰店
海博天猫旗舰店




一、培养基用途:
用于克罗诺杆菌的选择性增菌培养。
二、原理:
胰蛋白胨在培养基为微生物生长提供所需的碳源、氮源、维生素、氨基酸及生长因子;氯化钠维持渗透压;磷酸盐提供相对稳定的酸碱缓冲体系,月桂基磷酸钠抑制非大肠菌群类细菌的生长
按照GB4789.28-2024《食品安全国家标准 食品微生物学检验 培养基和试剂的质量要求》中改良月桂基硫酸盐胰蛋白胨肉汤-万古霉素(mLST-vm)质量控制方法,与旧版国标GB4789.28-2013相比,存在一点改动,新版国标删除了大肠埃希氏菌ATCC 25922,将旧版国标的附录D和附录E合并为新版的附录F一种质量控制方法。现按照新版国标对其进行检测。
三、培养基成分
|
成分 |
含量(g/L) |
|
胰蛋白胨 |
20.0 |
|
氯化钠 |
34.0 |
|
乳糖 |
5.0 |
|
磷酸氢二钾 |
2.75 |
|
磷酸二氢钾 |
2.75 |
|
月桂基硫酸钠 |
0.1 |
|
pH 6.8±0.2 25℃ |
|
四、操作方法
1、称取本品64.6g,加热溶解于1000ml蒸馏水中,分装锥形瓶,每瓶100ml,121℃高压灭菌15分钟,冷却至45-50℃时,每100ml培养基加入过滤除菌的万古霉素(1mg/ml)1支,混匀分装无菌试管,每管10ml备用。
2、制备工作菌悬液。
3、接种
目标菌(阪崎克罗诺杆菌ATCC 29544):接种10CFU-100CFU/管,接种体积不超过1mL,接种两个平型管。同时将1mL菌悬液(与试管同一稀释度)倾注平板(或适宜稀释度0.1mL涂布平板)接种两个平板,做接种量计数用。
非目标菌(粪肠球菌ATCC 29212):接种1000CFU-5000CFU/管,接种体积不超过1mL,接种两个平型管。同时将1mL菌悬液(比待测培养基试管接种小10-100倍稀释度)倾注平板(或适宜稀释度0.1mL涂布平板)接种两个平板,做接种量计数用。

图一: mLST-vm培养基44±0.5℃培养24±2小时后
4、44±0.5℃培养24±2小时后转接平板。
目标菌(阪崎克罗诺杆菌ATCC 29544):吸取10ul培养液均匀涂布或螺旋涂布到阪崎肠杆菌显色平板。(注:此处与旧版国标不同,旧版国标为取10ul培养液划线接种至阪崎肠杆菌显色培养基)
非目标菌(粪肠球菌ATCC 29212):吸取10ul培养液均匀涂布或螺旋涂布到非选择性平板上(如:TSA)。
5、将转接后的平板置于36±1℃培养24±2小时。

图二:试管转接平板后试验现象
五、实验结果
|
质控菌株 |
菌株编号 |
接种量(CFU) |
质量评定标准 |
|
阪崎克罗诺杆菌 |
ATCC 29544 |
10-100 |
转接后在阪崎肠杆菌显色培养基上为蓝绿色菌落,菌落数应>10CFU |
|
粪肠球菌 |
ATCC 29212 |
1000-5000 |
转接后在TSA上菌落数应<100CFU |
相关产品:
相关标准:
GB4789.28-2024《食品安全国家标准 食品微生物学检验 培养基和试剂的质量要求》
注:本文属海博生物原创,未经允许不得转载。
| 相关文章: | ||



